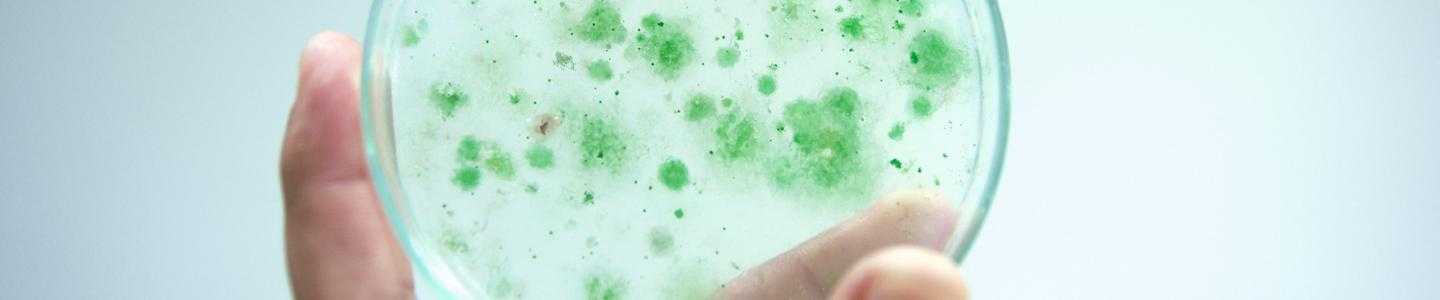
BlogHeroImg_Six Strategies for Controlling Salmonella

Non-typhoidal Salmonella is one of the most common foodborne illnesses “with an estimated 93.8 million illnesses, of which an estimated 80.3 million are foodborne, and 155,000 deaths each year” (Majowicz et al). It is estimated that the infection “imposes an estimated $3.7 billion in economic burden in a typical year” (2015 USDA Economic Research Service report titled “Economic Burden of Major Foodborne Illnesses Acquired in the United States”).
Nontyphoidal Salmonella bacteria originates in poultry, pigs, and cattle (plus many other animals) and can be passed through each stage in the farm-to-fork supply chain. It is also possible for food handlers to cause contamination and for sterile food contact surfaces to become contaminated by microbial particles in the air. As a result, good hygiene and sanitation are critical throughout the entire process.
Controlling and managing Salmonella in food production factories is down to good manufacturing processes coupled with comprehensive sanitation plans. Here are six strategies to help you stay on top of Salmonella.
Sanitary Design
The European Hygienic Engineering & Design Group (EHEDG) and 3-A Sanitary Standards Inc recommend similar best practices in the design of the food production environment to reduce the risk of contamination. For example, all surfaces must be accessible for cleaning, avoid any right angles on equipment installations, and ensure continuous welding with no indents or imperfections.
Drainage Design
“Drainage is a critical component affecting the hygienic performance of food production. Effective drainage helps mitigate hazards from the external environment and is central to the safe and hygienic operation internally” (ACO brochure: Drainage Management for the Food & Beverage Industry).
The importance of drainage in protecting against microbiological contamination in the processing hall is drastically underestimated. All soils, contaminants, chemicals and even food waste converge in the drains which are typically open systems that run across the whole site.
All drains should have removable covers to allow easy access for frequent cleaning and sanitizing. A foam or a gel with added quaternarium ammonium compounds is recommended. It is also important to keep in mind the design of the drainage network. For example, are all condensate pipes effectively transporting moisture to the drains? Are drains under the processing conveyors collecting all run-off? Poor drainage management will leave the area susceptible to microbial contamination.
Doorway Sanitation
Employee movement is one of the main vectors for spreading microbes. Installing a doorway sanitizing system removes the onus from the individual and ensures a fixed and consistent application. Door sanitizing systems can be timer or sensor activated and will typically use a dual cationic quaternary compound.
Fogging
It is important to avoid high pressure (<40 bars) cleaning sprays as they can cause microbial particles including Salmonella and other bacteria to aerosolize and spread across the production hall. Instead, fogging can be used to disinfect (sanitize) the surfaces in the room. Fogging is especially effective when there is a high turnover of room air, and there are hard-to-reach surfaces such as on top of equipment, pipe exteriors and hangers, ledges, etc.
Disinfectant (Sanitizer) Rotation
Disinfectant (sanitizer) rotation is recommended to prevent the development of microbial reduced susceptibility to the biocide used for the disinfection (sanitization) step. Additionally, altering the microenvironment (pH and mode of biocidal action) will reduce the development of Salmonella biofilm formation.
Continuous Learning
Good manufacturing processes and manual cleaning plans are only as effective as the personnel who are performing them. All employees who come into contact with food processing and handling must be correctly trained and it is recommended that the wider workforce is also trained to increase awareness of contamination sources and improve on personal hygiene behaviours. Retraining and regular refresher courses are also advised to keep food safety at the forefront and maintain good standards.
The online Diversey Hygiene Academy contains training modules dedicated to:
- Salmonella Management for Food Plants
- Good Manufacturing Processes (GMP) and Personal Hygiene for Food Plants
- Principles of Hygiene and Sanitation in Food and Beverage Processing
- Hygienic Design Principles for Food and Beverage Plants